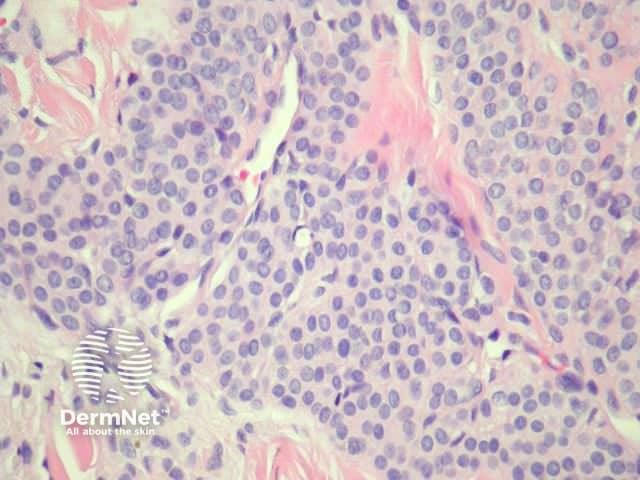
Figure 2
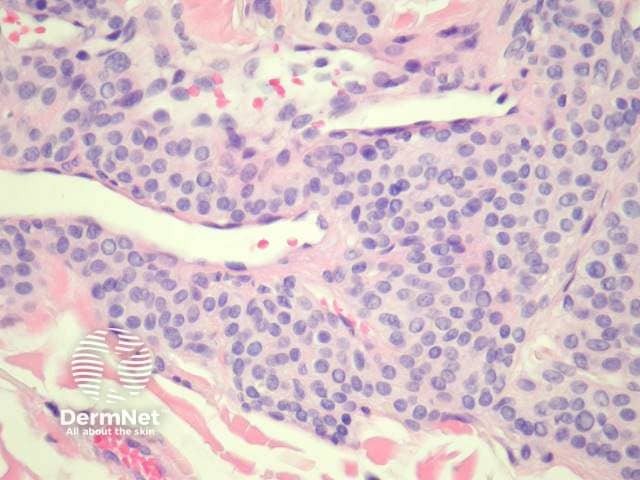
Figure 3
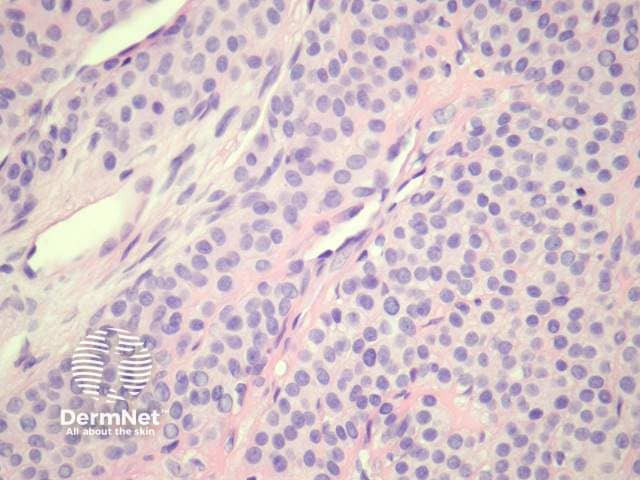
Figure 4

Main menu
Common skin conditions
NEWS
Join DermNet PRO
Read more
Quick links
Lesions (benign) Diagnosis and testing
Author: Dr Harriet Cheng BHB, MBChB, Dermatology Registrar, Waikato Hospital, Hamilton, New Zealand; Duncan Lamont, Department of Pathology, Waikato Hospital, Hamilton, New Zealand; Patrick Emmanuel, Dermatopathologist, Auckland, New Zealand, 2013.
Glomus tumours are painful. They arise from the neuromyoarterial glomus cells found in the fingers and palms. The normal counterpart from which these tumours arise is the Suquet-Hoyer canal. The clinical lesion is a solitary 1-2 cm reddish blue papule in a young adult.
Glomus tumours are dermal, well circumscribed and consist of small vessels surrounded by glomus cells (Figure 1). Glomus cells have bland round to oval nuclei, pale eosinophilic cytoplasm and clearly defined cell margins (Figure 2, 3, 4). Mitotic figures and pleomorphism should not be prominent.

Figure 1
Figure 2
Figure 3
Figure 4

Figure 5
Glomus cells are positive for SMA and muscle-specific actin. Myosin may be positive. CD34 and CD31 are positive in endothelial cells; glomus cells are usually negative (figure 5, CD31 stain).
Glomuvenous malformation (glomangioma): Vascular component is more prominent and with dilated vessels. Thrombosis and phlebolith formation may be evident.
Eccrine spiradenoma: Distinguished by presence of two cell populations, positivity for epithelial markers and focal ductal differentiation.
Intradermal naevus: Glomus cells can sometimes resemble naevomelanocytes. Naevus cells are positive with S100 and Melan-A